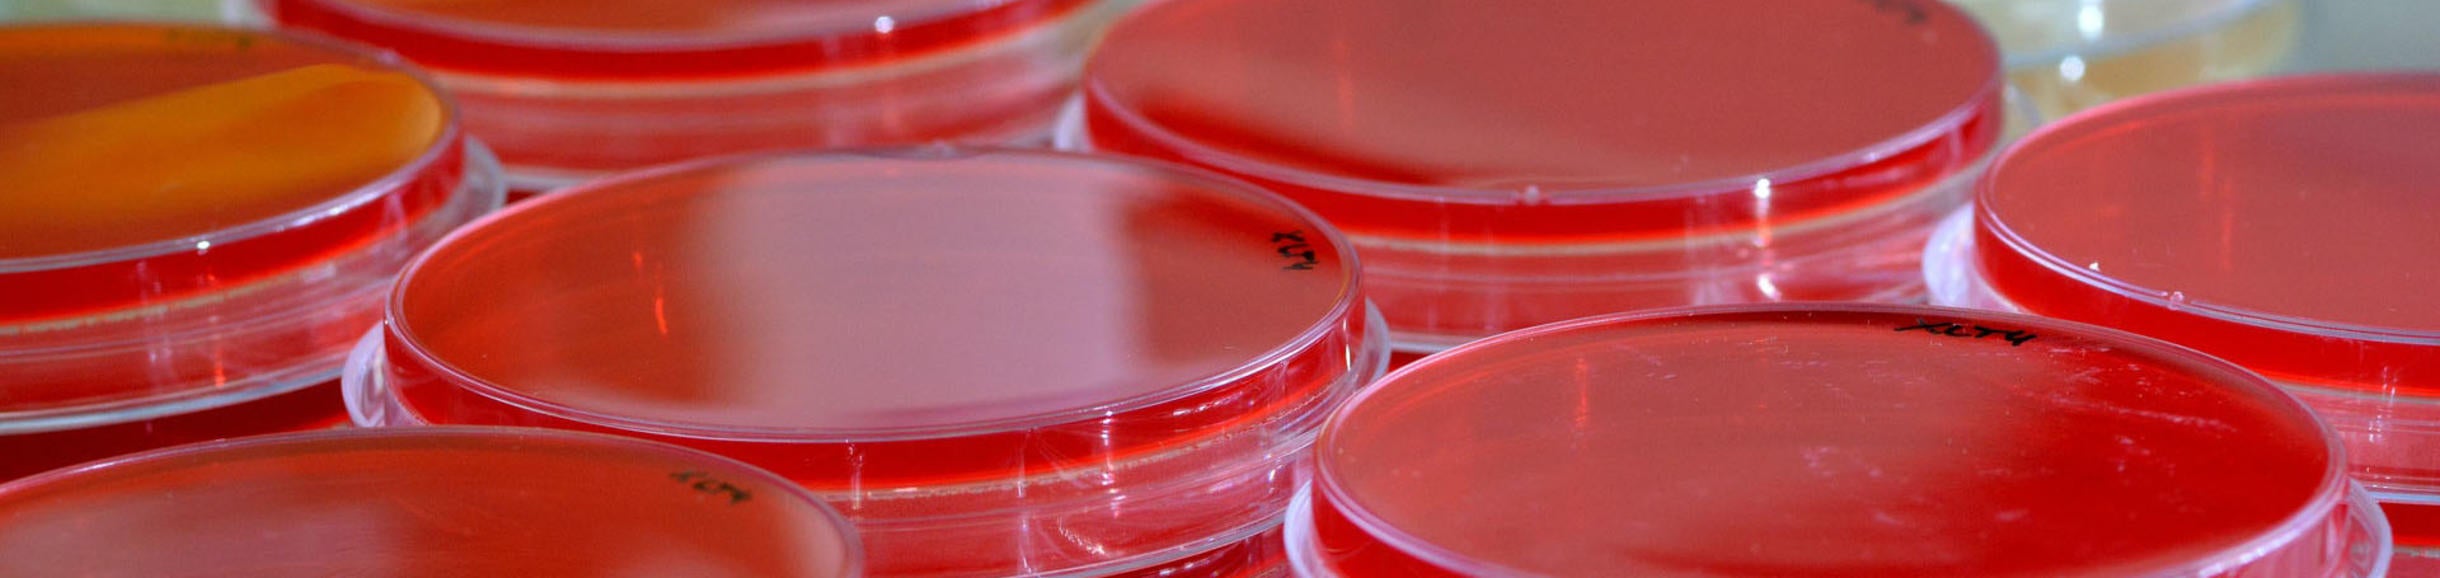
Petri dish

The UCR Microbiome “Initiative,” bring together scholars from across campus including the College of Natural and Agricultural Sciences (CNAS), the Bourns College of Engineering (BCOE) and the School of Medicine (SOM). Members include over 100 scholars from 22 different labs/PIs, 9 graduate programs, 10 departments, 3 colleges and 3 centers.
Directors UCR Microbiome Initiative
Advisory Board
Scholars Working on Microbiomes in Human Health and Diseases
Scholars Working on Agricultural and Plant Systems
Scholars Working on Environmental Microbiome
Scholars Working on Animal Microbiomes in Natural Systems
MICROBIOME INITIATIVE MEMBERS
Last Name |
First Name |
Title |
|
|
Adams |
Julia |
Graduate Student, Plant Biology |
Jadam013@ucr.edu |
|
Aggarwal |
Taruna |
Assistant Specialist, Nematology |
Taruna.aggarwal@ucr.edu |
|
Alavi |
Salma |
Ph.D. Student, Microbiology |
Salav002@ucr.edu |
|
Anderson |
Micheal |
CNAS Divisional Dean, Agriculture and Natural Resources |
Michael.anderson@ucr.edu |
|
Argueta |
Donovan |
Graduate Student in Bioengineering – Dr. DiPatrizio Lab |
Dargu002@ucr.edu |
|
Arpaia |
Mary Lu |
Extension Subtropical Horticulturist |
mlarpaia@ucanr.edu |
|
Bik |
Holly |
Assistant Professor of Nematology |
Holly.bik@ucr.edu |
|
Blacutt |
Alex |
Graduate Student |
|
|
Blaha |
Gregor |
Assistant Professor, Department of Biochemistry |
Gregor.blaha@ucr.edu |
|
Borkovich |
Katherine |
Chair and Professor, Dept. of Microbiology & Plant Pathology |
Katherine.borkovich@ucr.edu |
|
Borneman |
James |
Professor, Microbiology & Plant Pathology |
Borneman@ucr.edu |
|
Canale |
Vinicius |
Ph.D. Student, Department of Biochemistry |
Vinicius.canale@email.ucr.edu |
|
Canova |
Alyssa |
Student |
|
|
Carter-House |
Derrek |
Ph.D. Student, Microbiology and Plant Pathology |
Dcart001@ucr.edu |
|
Castro |
Claudia |
Ph.D. Student, Microbiology |
Ccast036@ucr.edu |
|
Cheloufi |
Sihem |
Assistant Professor, Department of Biochemistry |
Cheloufi@ucr.edu |
|
Chen |
Hao |
Ph.D. Student, Computer Science |
Hchen069@ucr.edu |
| Collas-Collazo | Margarita | Professor, MCSB | mcur@ucr.edu |
|
Collins |
Courtney |
Ph.D. Student, Botany and Plant Sciences |
Courtneygrace125@gmail.com |
|
Davis |
Nicole |
Deputy Director, CE-CERT |
Nicole@engr.ucr.edu |
|
Deol |
Poonamjot |
Assistant Project Scientist |
Pdeol001@ucr.edu |
|
Deyett |
Ella |
Ph.D. Student, GGB |
Elizabethdeyett@gmail.com |
|
Diez |
Jeff |
Assistant Professor, Dept. of Botany and Plant Sciences |
Jeffreyd@ucr.edu |
|
Dinges |
Meredith |
Post Doc. Analytical Chemistry |
mding002@ucr.edu |
|
DiPatrizio |
Nicholas |
Assistant Professor, Biomedical Sciences |
ndipatri@ucr.edu |
|
Donohue |
Jordan |
Ph.D. Student, Neuroscience |
Jordandonohue1990@gmail.com |
|
Ellstrand |
Norm |
Distinguished Professor of Genetics, Director CAFÉ, Johnson Chair |
Norman.ellstrand@ucr.edu |
|
Erudaitius |
Dieanira |
Graduate Student in Bioengineering |
Derudait@gmail.com |
| Focht | Dennis | Professor Emeritus | dennis.focht@ucr.edu |
|
Fogel |
Marilyn |
Wilbur M. Mayhew, Professor of Geo-Ecology and Director, EDGE |
Marilyn.fogel@ucr.edu |
|
Freedman |
Kevin |
Assistant Professor, Dept. of Bioengineering |
Kfreedman@lbl.gov |
|
Gachomo |
Emma |
Assistant Professor, Dept. of Plant Pathology & Microbiology |
Egachomo@ucr.edu |
|
Ginnan |
Nichole |
Ph.D. Student, Plant Pathology & Microbiology |
Nginn001@ucr.edu |
|
Girgis |
Kyrillos |
Student, Department of Biology |
|
|
Gu |
Jun |
|
|
|
Haberer |
Elaine |
Associate Professor, Electrical and Computer Engineering Department |
Haberer@ece.ucr.edu |
|
Hale |
Amanda |
Microbiology Graduate Student – Purcell Lab |
Amandarhale@gmail.com |
|
Hsaio |
Ansel |
Assistant Professor, Plant Pathology & Microbiology |
ansel.hsiao@ucr.edu |
|
Jackson |
Denise |
Graduate Student, Microbiology |
Denise.jackson@email.ucr.edu |
| Jeske | Daniel | Professor of Statistics, Department of Statistics | daniel.jeske@ucr.edu |
|
Kagda |
Meedakshi |
Post Doc, Dept. of Cell Biology & Neuroscience |
Mkagd001@ucr.edu |
|
Kaloshian |
Isgouhi |
Professor and Chair, Department of Nematology |
Isgouhi.Kaloshian@ucr.edu |
|
Keeler |
Anerea |
Ph.D. Student, EEOB |
Andrea.keeler@ucr.edu |
|
Kim |
Dohyup |
Ph.D. Student, Entomology |
Dkim246@ucr.edu |
| Kim | Gloria | Assistant Professor of Media and Culture Studies | gloriak@ucr.edu |
|
Kim |
Jane |
Graduate Student – Martins-Greene |
|
|
King |
Stephanie |
Ph.D. Student, Division of Biomedical Sciences |
Hkiss001@ucr.edu |
|
Kissinger |
Hannah |
Ph.D. Student, Microbiology |
Ekozl001@ucr.edu |
|
Kozlova |
Elena |
Ph.D. Student MCSB |
Karinel@ucr.edu |
|
Le Roch |
Karine |
Professor, Department of Molecular Cell and Systems Biology |
Llege001@ucr.edu |
|
Leger |
Laura |
Ph.D. Student, Entomology |
Huinanliu@engr.ucr.edu |
|
Liu |
Huinan |
Associate Professor, Dept. of Bioengineering |
Mloui007@ucr.edu |
|
Lo |
David |
Distinguished Professor of Biomedical Sciences, and Senior Associate Dean |
david.lo@medsch.ucr.edu |
|
Louis |
Monica |
Ph.D. Student, EEOB |
|
|
Lytle |
Christian |
Associate Professor and Associate Dean, School of Medicine |
Christian.lytle@ucr.edu |
|
Macbeth |
John |
Ph.D. Student, Biomedical Sciences |
Jmacb001@ucr.edu |
|
MacWillian |
Jacob |
Graduate Student, Biochemistry |
Jacob.macwilliams@email.ucr.edu |
|
Maltz |
Mia |
Post Doc, Microbiology |
|
|
Mauck |
Kerry |
Assistant Professor of Entomology |
Kerry.mauck@ucr.edu |
|
McClain |
Nathan |
Ph.D. Student, Microbiology |
Nkmclain@gmail.com |
|
McFrederick |
Quinn |
Assistant Professor of Entomology |
Quinnmc@ucr.edu |
|
McGiffen |
Milt |
Plant Physiologist, Dept. of Botany and Plant Sciences |
Milt@ucr.edu |
|
MengYuan |
Xi |
|
|
|
Nabity |
Paul |
Assistant Professor, Botany & Plant Sciences |
Paul.nabity@ucr.edu |
|
Nakamoto |
Bobby |
Ph.D. Student, Earth Sciences |
Bnaka004@ucr.edu |
|
Nightingale |
Sarah |
Senior Public Information Officer, University Communications |
Sarah.nightingale@ucr.edu |
|
Noll |
Jessica |
Ph.D. Student, Biomedical Sciences |
Jessica.noll@medsch.ucr.edu |
|
Ochoa |
Rosibel |
Assistant Vice Chancellor, Research and Economic Development |
Rosibel.ochoa@ucr.edu |
|
Pagliacca |
Deborah |
Assistant Project Scientist and Managing Director of CAFÉ |
deborahp@ucr.edu |
|
Peacock |
Beth |
Graduate Student, Microbiology and Plant Pathology |
Beth.b.peacock@gmail.com |
|
Perez |
Daniel |
Ph.D. Student, Microbiology |
Dpere040@ucr.edu |
|
Periera |
Tiago Jose |
Post Doc, Dept. of Nematology |
Tiago.pereira@ucr.edu |
|
Piña |
Michael |
Ph.D. Student, Plant Biology |
Michaelrpina@gmail.com |
|
Pittalwala |
Iqbal |
Senior Public Information Officer, University Communications |
Iqbal.pittalwala@ucr.edu |
|
Pombubpa |
Nuttapon |
Ph.D. Student, Plant Pathology & Microbiology |
Npomb001@ucr.edu |
|
Porter |
Angela |
Ph.D. Student, Microbiology |
Angelamanci1@gmail.com |
|
Purcell |
Jessica |
Professor of Entomology |
Jessica.purcell@ucr.edu |
|
Quides |
Kenjiro |
Ph.D. Student, EEOB |
Kquid001@ucr.edu |
|
Roper |
Caroline |
Associate Professor, Dept. of Microbiology & Plant Pathology |
Caroline.roper@ucr.edu |
|
Rothman |
Jason |
Ph.D. Student, Microbiology |
Jroth002@ucr.edu |
|
Ruegger |
Paul |
Post Doc, Microbiology & Plant Pathology |
Paulruegger@gmail.com |
|
Russel |
Kaleigh |
Ph.D. Student, Entomology |
Kaleigh.russell@ucr.edu |
|
Sachs |
Joel |
Professor, Dept. of Evolution, Ecology and Organismal Biology |
Joel.sachs@ucr.edu |
|
Sayoc |
Anica |
Ph.D. Student, Biomedical Sciences |
Asayo001@ucr.edu |
|
Schneider |
Bryan |
Director of Communications CNAS |
Bryan.schneider@ucr.edu |
|
Schurkman |
Jacob |
Graduate Student, School of Education |
|
|
Schwab |
Stuart |
Graduate Student, Evolution, Ecology & Organismal Biology |
Stuart.schwab@email.ucr.edu |
|
Sladek |
Frances |
Divisional Dean of Life Sciences, and Professor of Cell Biology and Toxicologist |
Lifescidean@ucr.edu |
|
Stajich |
Jason |
Professor and Director, Microbiology Graduate Program, Dept. of Microbiology and Plant Pathology |
Jason.stajich@ucr.edu |
|
Suh |
Brian |
Director, Office of Technology Commercialization |
Brian.suh@ucr.edu |
|
Tawdros |
Shirley |
Undergraduate Student |
|
|
Thairu |
Margaret |
Ph.D. Student, Entomology |
Mthai005@ucr.edu |
|
Wang |
Yan |
ZyGoLife Post Doc Fellow |
Yanwang@ucr.edu |
|
Wendlandt |
Camille |
Ph.D. Student, Plant Biology |
Cwend001@ucr.edu |
|
West |
Mari |
Graduate Student, Entomology |
Mari.west@email.ucr.edu |
|
Westbrook |
Jeanette |
Director Support, Edge Institute |
Jeanette.westbrook@ucr.edu |
|
Wilson |
Gillian |
Chair of the RED Advisory Committee, and Professor, Dept. of Physics and Astronomy |
Gillian.wilson@ucr.edu |
|
Yee |
Grace |
Senior Licensing Officer, Officer of Technology Commercialization |
Grace.yee@ucr.edu |
|
Zhong |
Liang |
|
|
|
Zhong |
Wenwan |
Professor, Department of Chemistry |
Wenwan.zhong@ucr.edu |

.png)




.png)



.png)
.png)
_0.png)


_1.png)